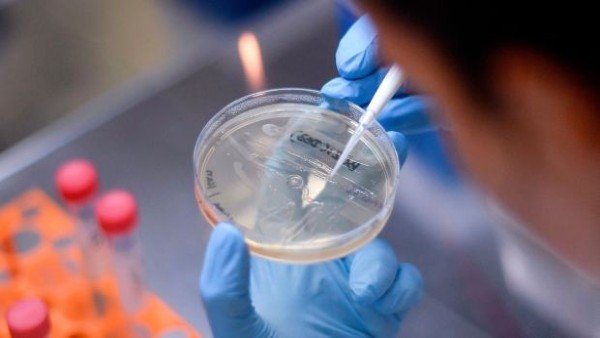
Vaccine

ICMR द्वारा कोरोना वैक्सीन के लिए डेडलाइन देने को IASC ने कहा अव्यवहारिक
ICMR द्वारा कोरोना वैक्सीन के लिए डेडलाइन देने को IASC ने कहा अव्यवहारिक
बेंगलुरु। इंडियन काउंसिल फॉर मेडिकल रिसर्च (ICMR)ने कोविड-19 की वैक्सीन कोविड-19 की वैक्सीन तैयार करने के लिए 15 जनवरी डेडलाइन रखी हैं। जिस पर प्रतिक्रिया देते हुए बेंगलुरु स्थित इंडियन एकेडमी ऑफ साइंसेज ने कहा है कि ICMR ने 15 अगस्त तक की कोरोनावायरस संक्रमण के लिए एक वैक्सीन लॉन्च करने का लक्ष्य 'अव्यावहारिक' और 'हकीकत से परे बताया।

IASC ने कहा कि नि:संदेह वैक्सीन की तुरंत जरूरत है, लेकिन मानवीय जरूरत के लिए टीका विकसित करने के लिए चरणबद्ध तरीके से वैज्ञानिक पद्धति से क्लिनिकल परीक्षण की आवश्यकता होती है। जिसमें समय लगता हैं 'वैज्ञानिक मानकों से समझौता नहीं किया जा सकता। समय सीमा की घोषणा करना अव्यावहारिक है

बता दें एक निजी फार्मा कंपनी, भारत बायोटेक इंडिया लिमिटेड के सहयोग से इंडियन काउंसिल फॉर मेडिकल रिसर्च संयुक्त रूप से कोरोनावायरस या कोविद -19 के खिलाफ एक टीका विकसित कर रही है। देश में वैक्सीन की शुरूआत के लिए ICMR द्वारा 15 अगस्त का लक्ष्य रखा गया है। IASC ने कोरोना वैक्सीन के जल्द विकसिम करने और लोगों के लिए उपलब्ध करवाए जाने की सराहना की लेकिन उसका मत है इसके लिए डेड लाइन निर्धारित करना अव्यवहारिक हैं। वैज्ञानिकों ने वैक्सीन को लेकर की जा रही इस हड़बड़ी को लेकर अलर्ट किया है और कहा है कि यह वैश्विक स्तर पर स्वीकार्य मानकों के मुताबिक नहीं है। यह मानते हुए कि रोग के प्रसार को रोकने के लिए एक वैक्सीन की एक महत्वपूर्ण और तत्काल आवश्यकता है, वैज्ञानिकों के शरीर ने कहा कि मानव पर उपयोग के लिए एक वैक्सीन के विकास को वैज्ञानिक रूप से एक नैदानिक रूप से किए गए रेगुलर परीक्षणों की जरूरत है।

Click it and Unblock the Notifications